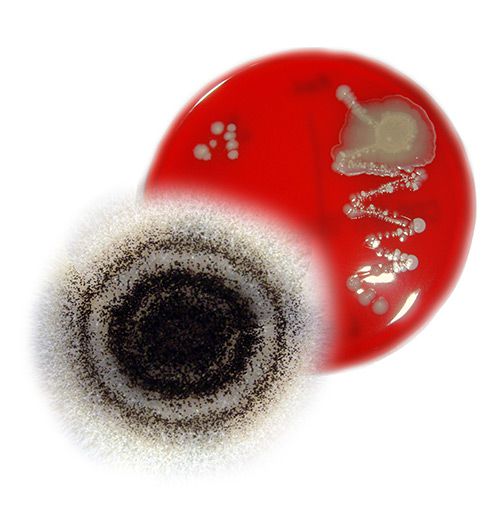

Der Tierarzt für Ihre Reptilien - Diagnostik & Therapie
Mikrobiologie
Bei der Mikrobiologie wird das Vorhandensein von Bakterien und Pilzen genauer untersucht. Dazu werden Tupferproben je nach Fragestellung von verschiedenen Bereichen des Reptils entnommen. Klassische Stellen sind Rachen und Kloake. Die gewonnenen Proben werden anschließend auf unterschiedliche Nährböden aufgetragen und im Wärmeschrank inkubiert. Anschließend erfolgt eine Auswertung mit Beurteilung der gewachsenen Keime. Bei Bedarf wird für eine anstehende antibiotische Behandlung ein Resistenztest durchgeführt, um das passende Antibiotikum für den individuellen Fall zu ermitteln.

Agarplatten
zur Anzucht der Proben. Je nach Agar werden gezielt Bakterien oder Pilze vermehrt.

Auftragen
der Proben zur Kultivierung des Probenmaterials Hilfe des Tupfers.
Ausgewertet
wird die Probe nach einer definierten Bebrütungszeit
Röntgen
Auf der Röntgenbildaufnahme kann man unter anderem die Knochen und Organe des Reptils beurteilen. Man sieht die Größe und Dichte der jeweiligen Strukturen und kann beurteilen, ob dies mit dem Bild eines gesunden Tieres übereinstimmt oder ob man für die jeweilige Fragestellung typische Anzeichen findet (z.B. Bruch bei Frakturverdacht oder Eier bei Verdacht auf Legenot). Bei unklaren Befunden kann ein Kontraströntgen zur besseren Abgrenzbarkeit des Magen-Darm-Traktes und damit zur Diagnosesicherung beitragen. Ein weiterer Vorteil des Röntgenbildes ist die deutliche Sichtbarkeit von metallischen Fremdkörpern. Bei Verdacht, ist hier das Röntgenbild ebenfalls Diagnostikum der Wahl.
Blutuntersuchung
Die Untersuchung des Blutes kann sehr hilfreiche Informationen über den aktuellen Gesundheitsstatus liefern. In der Blutchemie werden vor allem die einzelnen Parameter der Organe beurteilt, um so einen Eindruck von deren Funktionalität zu gewinnen. In der Hämatologie werden die Blutzellen selbst begutachtet. Hier finden sich z.B. Hinweise auf vorliegende Entzündungsreaktionen und ob diese chronischen oder akuten Charakter haben. Mit diesen Informationen kann man die Gesundheit im Rahmen von Routinekontrollen und Ankaufsuntersuchungen einschätzen oder bei Vorliegen von Erkrankungen wertvolle Informationen auf die Ursache und/oder den Schweregrad der Erkrankung erhalten.

Follikel auf dem Eierstock eines weiblichen Jemenchamäleons

Fast alle parasitologischen Proben müssen mittels
Mikroskop untersucht werden. Hier erfolgt die
Auswertung mittels HD-Kamera am Bildschirm.
Parasiten können anhand ihres Aussehens und ihrer Größe genau bestimmt werden. Folgend einige Beispiele:
-
![]()
Kokzidien
Sie gehören zu den Endoparasiten und sind vorwiegend im Darm zu finden. Sie können über eine Kotprobenuntersuchung nachgewiesen werden und sind deutlich kleiner als die Eier von parasitischen Würmern.
-
![]()
Milben
Milben können meist schon mit bloßem Auge als kleine Punkte erkannt werden. Mikroskopisch ist die Diagnose dann eindeutig.
-
![]()
Würmer
Verschiedene parasitische Würmer wie z.B. Oxyuren zählen ebenfalls zu den Endoparasiten. Auch ihr Nachweis gelingt über eine mikroskopische Kotprobenuntersuchung. Hier im Bild Oxyureneier.

Ein sehr bekannter Virus bei Reptilien ist zum Beispiel das Herpesvirus der Landschildkröten
Chirurgie
Chirurgische Eingriffe werden aufgrund verschiedener Ursachen wie z.B. Frakturen, Verletzungen oder Legenot durchgeführt und können sich mehr oder weniger invasiv gestalten. Individuell wird entschieden, welche Operationstechnik und welches Narkosemanagement am optimalsten auf den jeweiligen Einzelfall passt.
Therapie
Nach gestellter Diagnose sind je nach Fall therapeutische Maßnahmen nötig, um die Gesundheit des Reptils wieder herzustellen. Dies kann zuhause oder auch stationär erfolgen und wird individuell zwischen Tierbesitzer und Tierarzt besprochen.
Die Behandlung Zuhause
Die einfachsten Behandlungsarten für die Umsetzung durch den Besitzer selbst ist die orale Eingabe von Medikamenten. Manchmal sind aber auch Injektionen etc. nötig. Die Größe und die Zutraulichkeit des Tieres spielen bei der Verabreichung durch den Besitzer eine erhebliche Rolle. Je kooperativer das Tier ist, desto einfacher gestaltet sich die Verabreichung der Medikamente.

Pantherchamäleon während des stationären Aufenhalts










